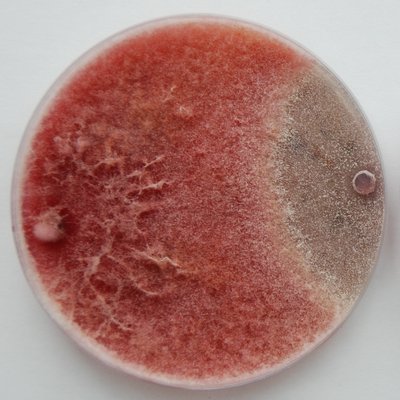

Contact Dr Carla Cervini
- Email: Carla.Cervini@cranfield.ac.uk
- Twitter: @CerviniCarla
- ORCID
- Google Scholar
- ResearchGate
Areas of expertise
- Agrifood Systems
- Food Quality
- Food Safety
Background
Carla graduated with a degree in Nutritional Biology from the University of Camerino (Italy) and then pursued an MSc in Human Nutrition at the University of Rome Tor Vergata (Italy). She earned a PhD in Translational Medicine and Food: Innovation, Safety, and Management from the Institute of Science of Food Production at the National Research Council in Bari (Italy), while registered at the University of Foggia (Italy). During her PhD, she focused on understanding the effects of potential climate change scenarios on the ecophysiological behavior of Aspergillus carbonarius in the South Italian wine production chain. As part of her PhD project she joined the Applied Mycology Group at Cranfield University as a visiting student, where she gained additional skills in fungal growth and incubation in in vitro systems to simulate climate change scenarios. She joined Cranfield University as a Research Fellow in Applied Mycology, contributing to the NutriNuts project (UKRI Innovate UK, 2019–2023), which aimed to develop research-based strategies for ensuring a safe peanut production chain from pre-harvest to storage in Ethiopia. She currently holds the position of Academic Fellow in Nutrition and Mycology within MCAM.
Research opportunities
Food safety
Human nutrition
Food Security
Current activities
Carla's current core research project is EWA-BELT: linking East and West African farming systems experience into a BELT of sustainable intensification funded by EU Horizon 2020. In this role she is leading a task on the development of effective pre- and post-harvest management strategies to avoid mycotoxin contmaination in stored food and feed. In 2024, she won a Global Challenges Research Fund (GCRF) project aiming at defining pre- and post-harvest measures to control aflatoxin occurrence in Ethiopian peanuts. In the same year, she also received a small grant from the British Mycological Society which allowed her to purchase laboratory consumables for identifying fungal species isolated from Ethiopian peanuts using molecular techniques.
In addition to her research, Carla is co-leading the development of the Magan Centre of Applied Mycology.
Publications
Articles In Journals
- Oyesigye E, Cervini C, Nkurunungi JB, Medina A & Mahuku G. (2026). Field experiment in Ugandan cassava stores reveals that slow release SO2 sheets suppress aflatoxigenic fungi, resulting in undetectable aflatoxin B1 levels. Food Control, 182
- Cervini C, Verma V, Verheecke-Vaessen C, Medina A & Magan N. (2026). First evidence of SO2-releasing bags controlling fungal growth, aflatoxins and cyclopiazonic acid contamination in unshelled peanuts. Letters in Applied Microbiology, 79(3)
- Bidzakin J, Graves AR, Cervini C, Bernard MJ, Chala A, .... (2026). Farmer perceptions of fungal spoilage and mycotoxin contamination in East and West Africa. World Mycotoxin Journal, 19(2)
- Crosta M, Cervini C, Medina A & Battilani P. (2025). Impact of simulated climate change conditions on Aspergillus flavus biocontrol effectiveness in peanut-based medium and peanut seeds. International Journal of Food Microbiology, 428
- Ingram B, Marín S, Kiaitsi E, Magan N, Verheecke-Vaessen C, .... (2025). Fusarium graminearum and zearalenone in wheat: a water activity–temperature model. Fungal Biology, 129(4)
- Llobregat B, Cervini C, González-Candelas L, Verheecke-Vaessen C, Ballester A-R, .... (2025). Will climate change affect growth and ochratoxin A production of putative biocontrol knockout strains of Aspergillus carbonarius?. International Journal of Food Microbiology, 439
- Sharma V, Cervini C, Verheecke-Vaessen C, Bandyopadhyay R, Medina A, .... (2025). Atoxigenic isolates of Aspergillus flavus effectively reduce cyclopiazonic acid in a sorghum-based matrix under simulated abiotic stress conditions. Letters in Applied Microbiology, 78(6)
- Yan Y, Wang K, Cervini C, Mao H, Wang Q, .... (2025). Recent Advances in Photoelectrochemical Biosensors Based on Novel Photoactive Materials and Detection Strategy for Agricultural Toxin: A Review. IEEE Sensors Journal, 25(19)
- Cervini C, Naz N, Verheecke-Vaessen C & Medina A. (2024). Impact of predicted climate change environmental conditions on the growth of Fusarium asiaticum strains and mycotoxins production on a wheat-based matrix. Journal of Food Microbiology, 416
- Oyesigye E, Cervini C, Mahuku G & Medina A. (2024). Potential impact of current agricultural practices on mycotoxin occurrence and mycotoxin knowledge along the cassava value chain in Uganda. Journal of Food Protection, 87(9)
- Oyesigye E, Cervini C, Oluwakayode A, Mahuku G & Medina A. (2024). First evidence on the occurrence of multi-mycotoxins and dietary risk exposure to AFB1 along the cassava value chain in Uganda. Mycotoxin Research, 40(4)
- Adepoju M, Verheecke-Vaessen C, Pillai LR, Phillips H & Cervini C. (2024). Unlocking the potential of teff for sustainable, gluten-free diets and unravelling its production challenges to address global food and nutrition security: a review. Foods, 13(21)
- Cervini C, Abegaz B, Mohammed A, Elias R, Medina A, .... (2023). Assessment of agricultural practices by Ethiopian women farmers: existence of gender disparities in access to mycotoxins training. World Mycotoxin Journal, 16(3)
- Mohammed A, Seid A, Terefe H, Cervini C & Verheecke-Vaessen C. (2022). Harvest and post-harvest handling practices associated with Fumonisin B1 Contamination in maize (Zea mays L.): dietary exposure and risk characterization in Eastern Ethiopia. Mycotoxin Research, 38(4)
- Cervini C, Verheecke-Vaessen C, He T, Mohammed A, Magan N, .... (2021). Improvements within the peanut production chain to minimize aflatoxins contamination: an Ethiopian case study. Food Control, 136(June)
- Ferrara M, Gallo A, Cervini C, Gambacorta L, Solfrizzo M, .... (2021). Evidence of the involvement of a cyclase gene in the biosynthesis of ochratoxin A in Aspergillus carbonarius. Toxins, 13(12)
- Cervini C, Gallo A, Piemontese L, Magistà D, Logrieco AF, .... (2020). Effects of temperature and water activity change on ecophysiology of ochratoxigenic Aspergillus carbonarius in field-simulating conditions. International Journal of Food Microbiology, 315
- Cervini C, Verheecke-Vaessen C, Ferrara M, García-Cela E, Magistà D, .... (2019). Interacting climate change factors (CO2 and temperature cycles) effects on growth, secondary metabolite gene expression and phenotypic ochratoxin A production by Aspergillus carbonarius strains on a grape-based matrix. Fungal Biology, 125(2)